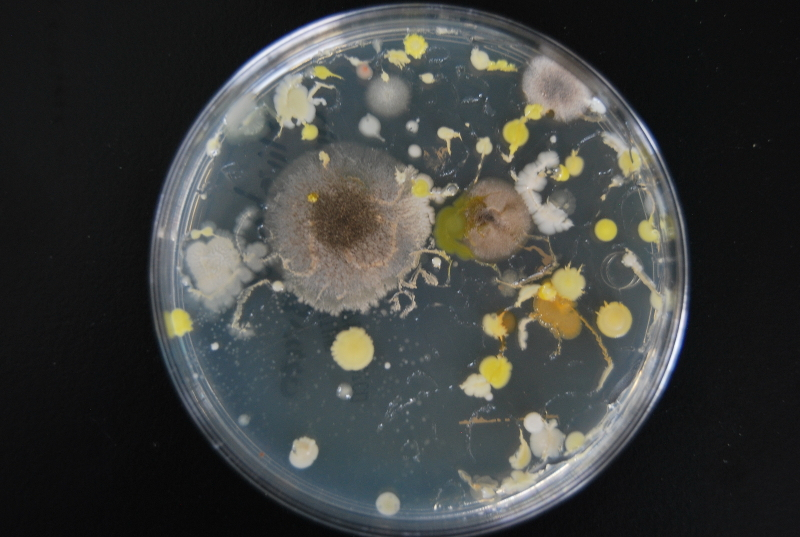
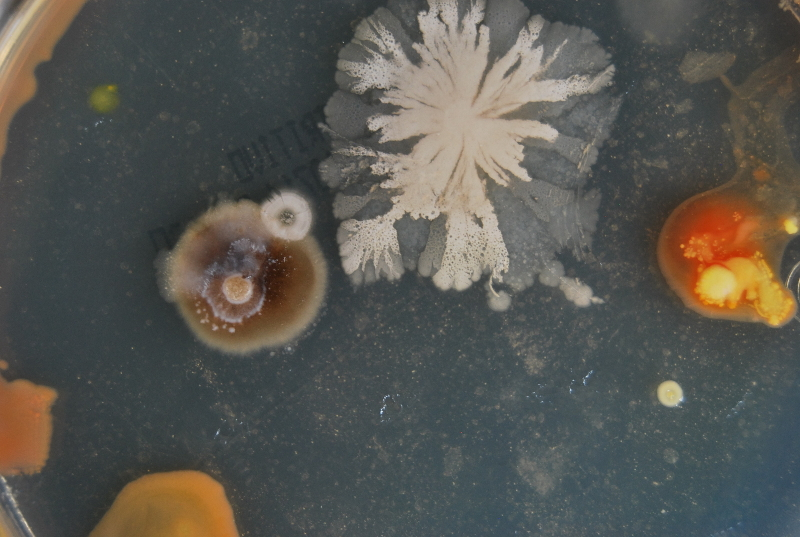

“La necesidad humana de naturaleza está vinculada no sólo a la explotación material del medio ambiente, sino también a la influencia de la naturaleza en nuestro bienestar emocional, estético, cognitivo e incluso en el desarrollo espiritual.”
Kellert, S. R. Y Wilson, E. O. (1993). The Biophilia Hypothesis
En su libro Biofilia, Edward O. Wilson postuló que nuestra capacidad de maravillarnos por la vida es innata, porque nuestra evolución se dio por y en la naturaleza.
Esa facultad descrita por Wilson es transparente en las ocupaciones de Edith Medina, quien se define como artista biológica por trabajar con diferentes ámbitos de las ciencias, “no sólo microorganismos, sino con interacciones que se pueden dar hacia los materiales, la moda, la ropa y hacia cómo concebimos a la biología en un entorno social y político”, acotó la artista.
Edith Medina tiene estudios complementarios de arte y biología en la Universidad Oberta de Cataluña, de etnografía de objetos en la Plataforma de la Universidad de Harvard, así como de arte y nuevos medios en el Instituto Nacional de Bellas Artes.
Una vertiente de su labor es la biología creativa, que apuesta por caminos más allá de lo científico y desde la cual “una pieza artística puede indagar cómo van a ser nuestra relación en un futuro con los materiales, con la comida o cómo nos vamos a interrelacionar ante una crisis”.
Borrar fronteras entre conocimientos
En 2007, como pionera del bioarte en México, Edith Medina introducía en su artículo «Bioarte: una nueva fórmula de expresión artística»(1) al nuevo género dispuesto a “crear arte que usa a la vida como nuevo medio de comunicación”.
En los inicios del bioarte la experimentación se veía alimentada por el desarrollo de las ciencias vivas, área muy encendida a finales del siglo XX e inicios del siglo XXI, en donde la bioingeniería, sus tecnologías y promesas cuestionaron los límites de lo humano y lo natural.
Entonces tuvimos un despliegue de obras como las de Eduardo Kay, quien creó una flor que expresaba su ADN a través de «venas rojas» o la chaqueta de cuero de Oron Catts e Ionat Zurr, para la que se cultivaron células derivadas de células madre embrionarias de ratón.

Cabe destacar que desde el inicio de su carrera, hace 20 años, la artista mexicana Edith Medina trabaja con una noción: el conocimiento se produce desde diferentes experiencias, no siempre dentro de las academias y no todo el tiempo con los mismos procesos y fines.
Investigar como hilo conductor
En talleres, seminarios, investigaciones y prácticas varias desde el proyecto Biology Studio, del cual la artista es fundadora, articula reflexiones renovadas en torno a la materia viva, mismas que se construyen por su constante diálogo con otros campos de estudio como la ingeniería de materiales, la biotecnología, la biología, el diseño y la arquitectura.
Edith Medina comentó que, al investigar materiales, no hace una distinción tajante entre los procesos científicos y artísticos, pero lo que sí realiza es “una investigación muy formal, como en las áreas científicas y ciencias sociales. Hacemos el ejercicio de observación, generamos una hipótesis y una comprobación”.
También especificó que la vinculación al proceso creativo ocurre a partir de intenciones y que sin ser formalmente científicas estas tienen relevancia y rigor, además de “generar perspectivas, escenarios y especular sobre esos escenarios y sobre esos materiales en esos escenarios, lo que amplia estructuras”.

Sobre los programas que ofrece en Biology Studio(2), el primer estudio mexicano que vincula diseño, tradición, ciencia y naturalismo, explicó que enlazan “la ecología política, así como las nociones y construcciones humanas de la naturaleza, haciendo a la par una revisión de historia natural, no solo desde el enfoque científico sino desde otras latitudes”.
De hecho, su ejercicio como directora de Biology Studio ha cambiado sus relaciones con la vida y la naturaleza: “trabajar con ecólogos ha sido revelador, comparten que no hay nada natural porque todo de alguna u otra forma está intervenido”; esta noción le permite entenderse como parte de un sistema “soy una especie en este contexto como lo es un árbol, un ave o una hormiga, lo soy sin intentar establecer jerarquías, tenemos condiciones de vida e inteligencias diferentes, pero intento no verme encima de una escala”.
De forma constante los procesos de cotidianidad son abordados por la artista, por ello atiende a la biología que nos ronda, “me gusta vincular la realidad con conceptos científicos que abordamos muy a distancia y tener la posibilidad de vincularnos con un entorno no solo del espacio cotidiano, sino incluso del espacio íntimo, por ejemplo cómo me relaciono con una lágrima o cómo me relaciono con el polvo”.
“A lágrima viva”, un proyecto para cartografiar lo invisible
Muy cercano a lo íntimo está lo invisible, otro tema que Edith Medina aborda en su obra. Eso invisible está en su uso de lo microscópico y los microorganismos, pero también se revela con “aquello que es evidente, se ve, pero es invisibilizado, como pueden ser los materiales del cuerpo o los fluidos”.
Una de sus obras, expuesta en 2013, se relaciona tanto con estos temas, como con la microbiología científica y la bioquímica médica, se trata de “A lágrima viva: Fisiología biológico social de una lágrima” (3), que es una instalación artística en la que se trabajó con lágrimas a partir de la técnica de cultivo de microorganismos.
De 20 participantes que recolectaron sus lágrimas, un tercio obtuvo una muestra a la que se le pudo hacer un perfil bioquímico y bacteriológico. Además de un tubo para las muestras se les otorgó un manual de recolección y un cuestionario del llanto para “elaborar el perfil clínico y emocional”.

Las lágrimas fueron analizadas bajo un “protocolo bioquímico de localización de proteínas y actividad enzimática”. Fue por el análisis enzimático, posible a través del estudio de la lisozima (sustancia con propiedades antibióticas), que pudieron definir variaciones entre lágrimas.
En su blog, Edith Medina señala que dichas diferencias se podían percibir a simple vista. También tomó una muestra de las lágrimas que se esterilizaron e inocularon en cajas Petri, preparadas con nutrientes necesarios para el crecimiento de colonias bacterianas.

Crédito: Edith Medina 
Luego se produjo un antibiograma, que es una prueba para determinar la sensibilidad de los gérmenes a los antibióticos, en este caso «se vaciaban sobre papel filtro para generar halos de reacción antibiótica de la lisozima que variarian dependiendo del contenido bioquímico de cada lágrima, generando un trazo distinto en la ecología de la lágrima base, una especie de dibujo biológico con la conformación del llanto de cada donante».
La artista narró que para más allá de la propiedad científica de la lágrima y su propiedad antibiótica, ella habló de la realidad “en donde la lágrima cae en la mejilla y a través de esa lágrima que cae se construye una ecología».

«Me gustaba esa estructura de lo biológico social de la lágrima, de cómo se construye cuando alguien lo mira, cómo se va estructurando a partir de connotaciones que socialmente se van conformando, no por las categorías científicas sino por las categorías realmente de vinculación social, cómo se implican ambas y con esto hacer diferenciaciones», apuntó.
De este último proceso se desprende “Genealogía de una lágrima” (4), proyecto en el que a partir de microfotografías de diferentes momentos en el proceso de secado de sus lágrimas obtuvo dibujos.
Tecnologías locales y materiales especulativos
Edith Medina incluye en su ocupación el trabajo artesanal y la elaboración de herramientas buscando evidenciar que desde contextos locales existe una relación con los materiales y los artefactos inventados para relacionarnos con la materia, y que pese a su posibilidad como procesos tecnológicos o científicos no son reconocidos como tal.
Pues eso que puede ocurrir en la tradición de textiles o de generación de conocimientos fuera de la academia es tomado por la artista desde investigaciones rigurosas, íntimas y que apuestan por caminos novedosos que la ingeniería, la ciencia o la biología no toman, pero que al recorrerse ofrece lecturas diversas sobre nuestra relación con la materia viva.

Con Biology Studio y el Laboratorio de Arte Alameda realizó un taller de materiales especulativos, calificados así por ser realizados para escenarios futuros, en el taller exploraron métodos de manipulación y fabricación con biopolímeros, bacterias, vegetales, frutas y plantas.
Otro taller de la misma casa explora el textil bacterial o biotextil, campo al que la artista llegó como en infinidad de ocasiones de su carrera por su incansable curiosidad.
Los biotextiles proponen que organismos vivos como bacterias, levaduras y hongos, así como residuos orgánicos mediante procesos de fermentación, crecimiento o cultivo funcionen como fábricas de fibras textiles, por lo que además de su evidente poder de experimentación, para Medina este campo es «un ejercicio de perspectivas y escenarios que nos permite relacionarnos con lo que será y ya está siendo la industria, con tecnologías y contexto social incluídos».

Respecto al futuro de estos materiales indicó que “algunos tendrán mayor aceptación, salida y escalabilidad que otros, algunos solo han funcionado para abrir la puerta, especular escenarios y poder generar otros desarrollos, otros serán muy importantes y se usarán en los próximos ocho o diez años”.
Ser y tener referentes mujeres

Edith Medina considera importante enunciar nuevas visiones de mujeres y hacerlo fuera del ojo patriarcal en el cual se establecen estereotipos a las prácticas de las mujeres, por ello su trabajo implica revisiones más profundas de temas que se mal vinculan a lugares comunes cuando una mujer los trabaja.
Para reconstruir el escenario propone exponer a las mujeres en diferentes campos: “Es importante que las mujeres hablemos de nuestro trabajo, que demos referencias de otras mujeres, que nosotras nos volvamos referencias, porque las mujeres necesitamos más referencia de mujeres haciendo, ejerciendo y también visibilizando”.
Como compañeras de ideas tiene a cineastas, músicas, escritoras, poetas y artistas, algunas son Rosario Castellanos, Marie Curie, Sylvia Plath y Julia Watson, pero una muy presente es su abuela Camila, quien desde el ejemplo le compartió “que las mujeres podíamos liderar nuestros propios proyectos y nuestra vida”.
Su abuela Camila generó un negocio de semillas que Edith cuenta le brindó la ella las bases para trabajar con “conocimiento ancestral, con una relación hacia la tierra y los materiales”.
La materia que alerta Edith Medina en sus investigaciones y los apuntes que hace desde el arte son ejercicios que nos dan dimensión en un momento social en que nuestra relación con la naturaleza demanda atención, protección y nuevas relaciones, las ocupaciones de la artista nos ofrece intimidad y una oportunidad de relación con lo invisible.
Fuentes:
- http://www.revista.unam.mx/vol.8/num1/art01/ene_art01.pdf
- https://biologystudio.com.mx/portafolio/
- https://alagrimaviva.wordpress.com
- https://edithmedina.com/bio/
Imagen de portada: Cortesía Edith Medina

Deja un comentario